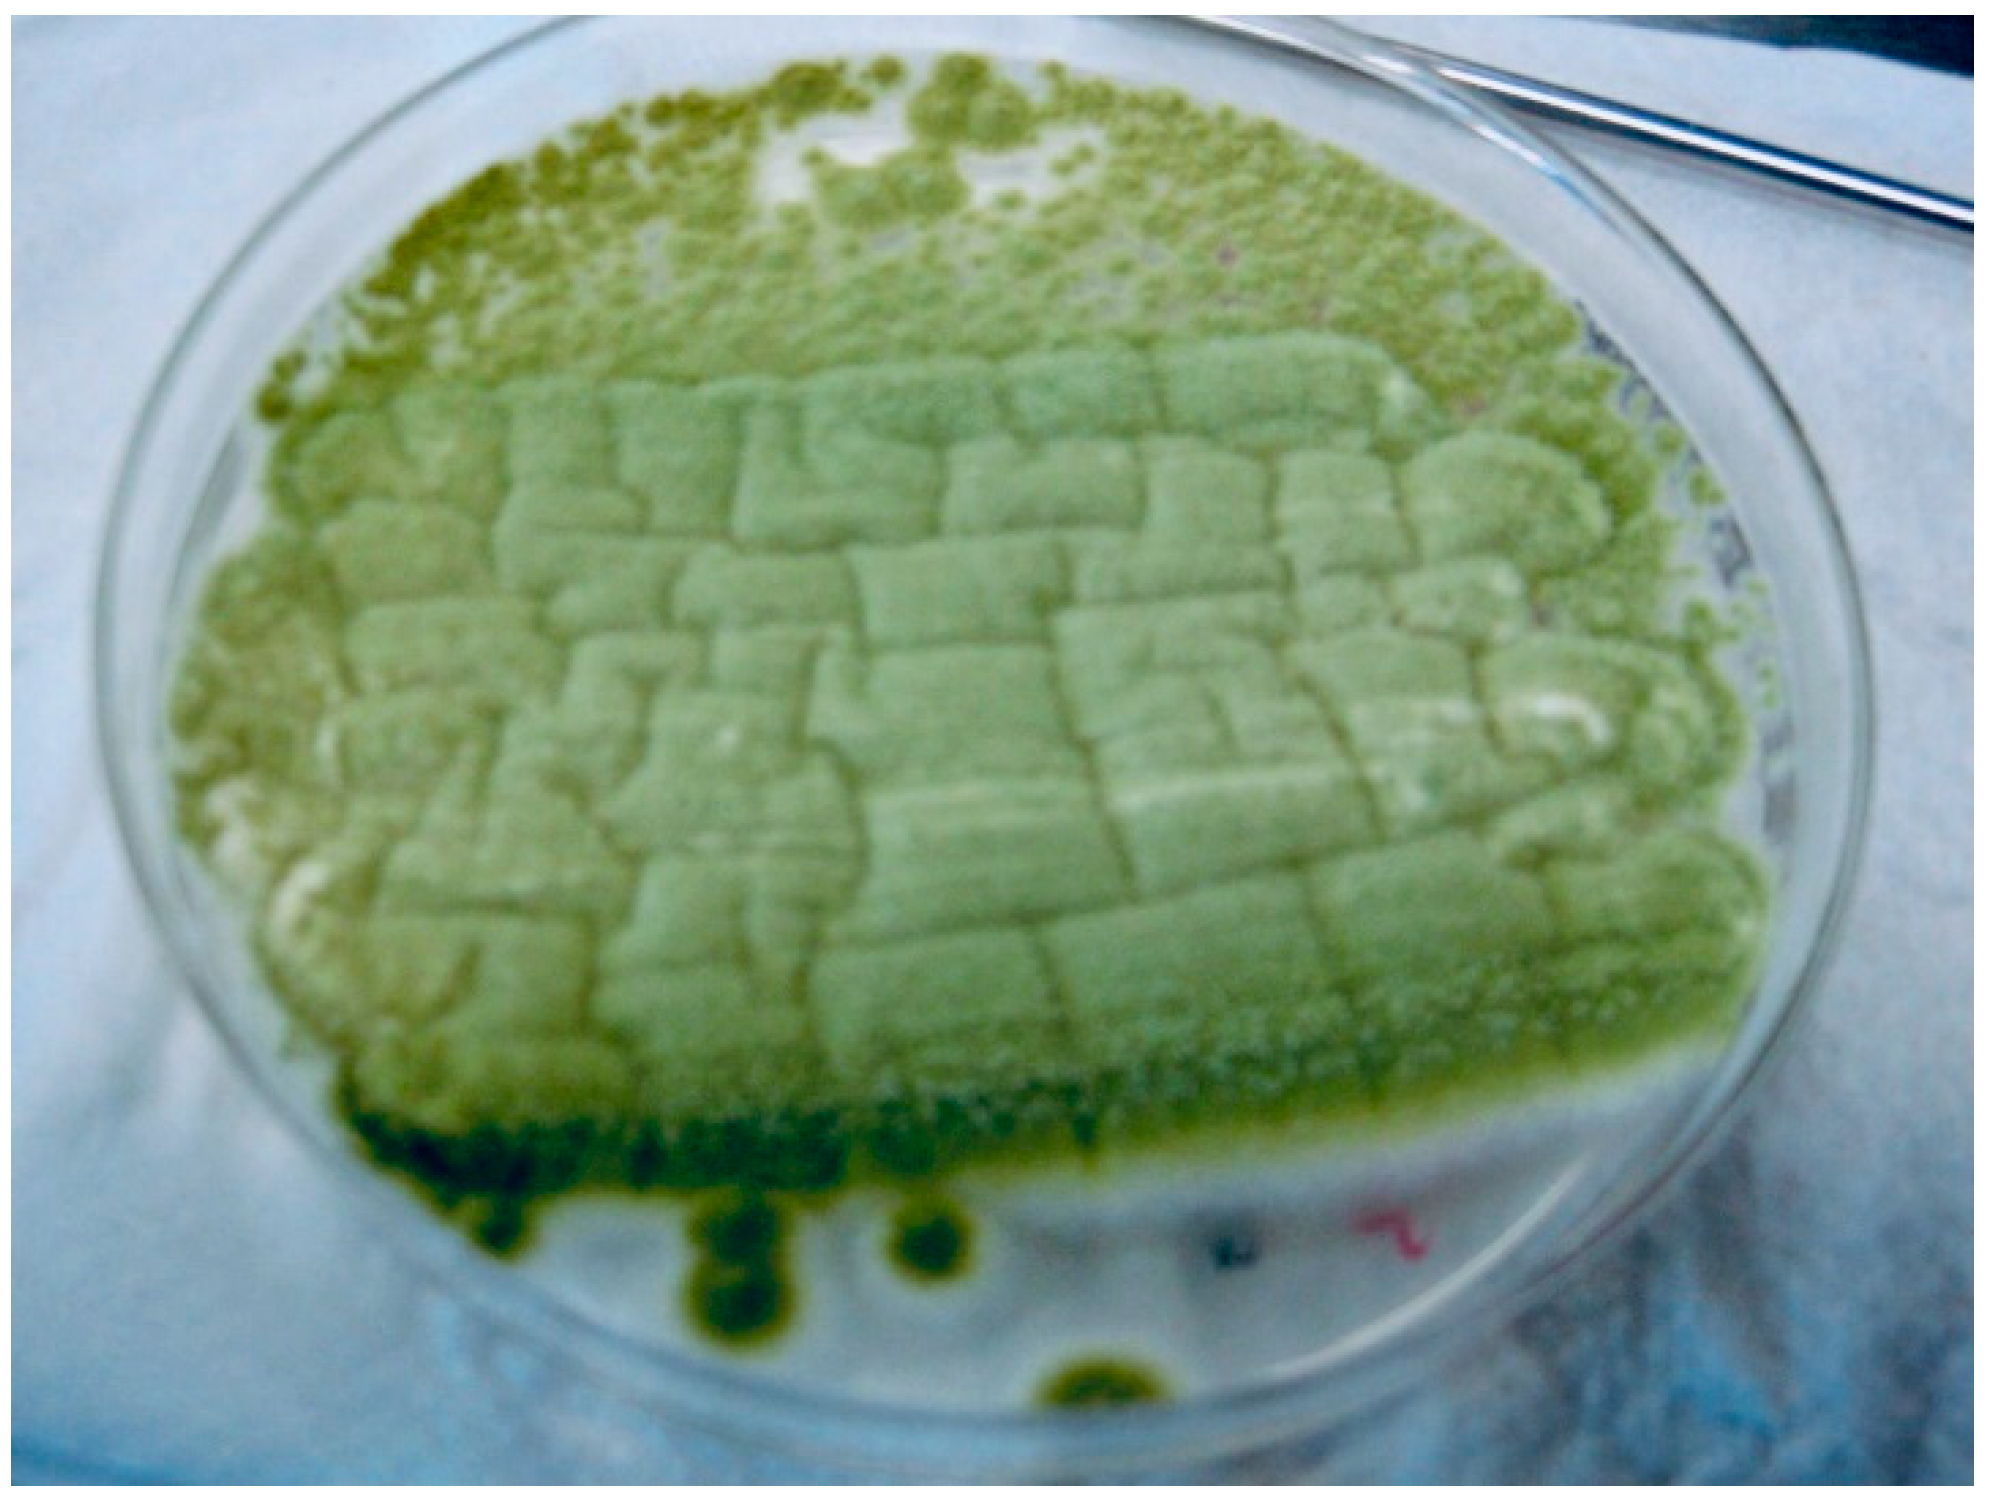
Jof 07 00877 g001 550

Mixed Etiology COVID-19 Associated Pulmonary Aspergillosis (CAPA)—A Case Report and Brief Review of the Literature
Abstract
:1. Introduction
2. Case Presentation
3. Discussion
Author Contributions
Funding
Institutional Review Board Statement
Informed Consent Statement
Data Availability Statement
Acknowledgments
Conflicts of Interest
References
- Blaize, M.; Mayaux, J.; Nabet, C.; Nabet, C.; Lampros, A.; Marcelin, A.-G.; Thellier, M.; Piarroux, R.; Demoule, A.; Fekkar, A. Fatal Invasive Aspergillosis and Coronavirus Disease in an Immunocompetent Patient. Emerg. Infect. Dis. 2020, 26, 1636–1637. [Google Scholar] [CrossRef]
- Lai, C.C.; Yu, W.L. COVID-19 associated with pulmonary aspergillosis: A literature review. J. Microbiol. Immunol. Infect. 2021, 54, 46–53. [Google Scholar] [CrossRef]
- Machado, M.; Valerio, M.; Álvarez-Uría, A.; Olmedo, M.; Veintimilla, C.; Padilla, B.; De La Villa, S.; Guinea, J.; Escribano, P.; Ruiz-Serrano, M.J.; et al. Invasive pulmonary aspergillosis in the COVID-19 era: An expected new entity. Mycoses 2021, 64, 132–143. [Google Scholar] [CrossRef]
- Rudramurthy, S.M.; Paul, R.A.; Chakrabarti, A.; Mouton, J.W.; Meis, J.F. Invasive aspergillosis by aspergillus flavus: Epidemiology, diagnosis, antifungal resistance, and management. J. Fungi 2019, 5, 1–23. [Google Scholar] [CrossRef] [Green Version]
- Larone, D.H. Medically Important Fungi. A Guide to Identification, 4th ed.; ASM Press: Washington DC, USA, 2002; pp. 266–268, 303. [Google Scholar]
- Kidd, S.; Halliday, C.; Alexiou, H.; Ellis, D. Descriptions of Medical Fungi, 3rd ed.; Newstyle Printing: Adelaide, Australia, 2016; pp. 12–18. [Google Scholar]
- Samson, R.A.; Visagie, C.M.; Houbraken, J.; Hong, S.-B.; Hubka, V.; Klaassen, C.H.W.; Perrone, G.; Seifert, K.; Susca, A.; Tanney, J.; et al. Phylogeny, identification and nomenclature of the genus Aspergillus. Stud. Mycol. 2014, 78, 141–173. [Google Scholar] [CrossRef] [Green Version]
- Donnelly, J.P.; Chen, S.C.; Kauffman, C.A.; Steinbach, W.J.; Baddley, J.W.; Verweij, P.; Clancy, C.J.; Wingard, J.R.; Lockhart, S.R.; Groll, A.H.; et al. Revision and update of the consensus definitions of invasive fungal disease from the european organization for research and treatment of cancer and the mycoses study group education and research consortium. Clin. Infect. Dis. 2020, 71, 1367–1376. [Google Scholar] [CrossRef] [PubMed] [Green Version]
- Mohamed, A.; Rogers, T.R.; Talento, A.F. COVID-19 associated invasive pulmonary aspergillosis: Diagnostic and therapeutic challenges. J. Fungi 2020, 6, 1–14. [Google Scholar] [CrossRef] [PubMed]
- Ku, Y.H.; Chan, K.S.; Yang, C.C.; Tan, C.K.; Chuang, Y.C.; Yu, W.L. Higher mortality of severe influenza patients with probable aspergillosis than those with and without other coinfections. J. Formos. Med. Assoc. 2017, 116, 660–670. [Google Scholar] [CrossRef] [PubMed]
- Cağlar, K.; Kalkancı, A.; Fidan, I.; Aydoğan, S.; Hızel, K.; Dizbay, M.; Poyraz, A.; Kuştimur, S. Investigation of interleukin-10, tumor necrosis factor-alpha and interferon-gamma expression in experimental model of pulmonary aspergillosis. Mikrobiyol. Bul. 2011, 45, 344–352. [Google Scholar] [PubMed]
- Arastehfar, A.; Carvalho, A.; van de Veerdonk, F.L.; Jenks, J.D.; Koehler, P.; Krause, R.; Cornely, O.A.; Perlin, D.S.; Lass-Flörl, C.; Hoenigl, M. COVID-19 associated pulmonary aspergillosis (CAPA)—From immunology to treatment. J. Fungi 2020, 6, 1–17. [Google Scholar] [CrossRef] [PubMed]
- Lamoth, F. Aspergillus fumigatus-related species in clinical practice. Front. Microbiol. 2016, 7, 1–8. [Google Scholar] [CrossRef] [PubMed] [Green Version]
- Hedayati, M.T.; Pasqualotto, A.C.; Warn, P.A.; Bowyer, P.; Denning, D.W. Aspergillus flavus: Human pathogen, allergen and mycotoxin producer. Microbiology 2007, 153, 1677–1692. [Google Scholar] [CrossRef] [PubMed] [Green Version]
- Colosi, I.A.; Cognet, O.; Colosi, H.A.; Sabou, M.; Costache, C. Dermatophytes and dermatophytosis in Cluj-Napoca, Romania—A 4-year cross-sectional study. J. Fungi 2020, 6, 154. [Google Scholar] [CrossRef] [PubMed]
- Nasir, N. COVID-19-associated pulmonary aspergillosis (CAPA) in patients admitted with severe COVID-19 pneumonia: An observational study from Pakistan. Emerg. Infect. Dis. 2020, 27, 766–770. [Google Scholar] [CrossRef] [PubMed]
- Abolghasemi, S.; Hakamifard, A.; Sharifynia, S.; Pourabdollah, M.; Hamed, T.; Tehrani, A. Fatal invasive pulmonary aspergillosis in an immunocompetent patient with COVID-19 due to Aspergillus terreus: A case study. Clin. Case Rep. 2021, 9, 2414–2418. [Google Scholar] [CrossRef] [PubMed]
- Marr, K.A.; Platt, A.; Tornheim, J.A.; Zhang, S.X.; Datta, K.; Cardozo, C.; Garcia-Vidal, C. Aspergillosis complicating severe coronavirus disease. Emerg. Infect. Dis. 2021, 27, 18–25. [Google Scholar] [CrossRef] [PubMed]
- Paramythiotou, E.; Dimopoulos, G.; Koliakos, N.; Siopi, M.; Vourli, S.; Pournaras, S.; Meletiadis, J. Epidemiology and Incidence of COVID-19-Associated Pulmonary Aspergillosis (CAPA) in a Greek Tertiary Care Academic Reference Hospital. Infect. Dis. Ther. 2021, 10, 1779–1792. [Google Scholar] [CrossRef] [PubMed]

| International Nonproprietary Name (INN) | Dose | Details |
|---|---|---|
| REMDESIVIRUM | 100 mg | Day 1–5 |
| VORICONAZOLUM | 200 mg | Day 5–14 |
| ACENOCUMAROLUM | 4 mg | Day 10–14 |
| INSULINUM GLARGINE | 14 UI | Day 1–14, adjusted according to glicemic profile |
| SPIRONOLACTONUM/FUROSEMIDUM | 50/20 mg | Day 1–14 |
| NEBIVOLOLUM | 5 mg | Day 1–14 |
| LEVOTHYROXINUM | 100 µg | Day 1–14 |
| BECLOMETASONUM/FORMOTEROLUM | 100/6 µg | Day 1–14 |
| DEXAMETHASONUM | 8 mg | Day 1–14 |
| FAMOTIDINUM | 20 mg | Day 1–14 |
| LACTOBACILLUS PARACASEI CNCM I-1572 | 3 g | Day 1–14 |
| ENOXAPARINUM | 60 mg/0.6 mL | Day 1–14 |
| DIGOXINUM | 0.5 mg | Day 1–14 |
| MONTELUKASTUM | 10 mg | Day 1–14 |
| AMBROXOLUM | 30 mg | Day 1–14 |
| CEFTRIAXONUM | 2 g | Day 1–10 |
| DOXYCYCLINUM | 100 mg | Day 1–10 |
| Day 1 | Day 2 | Day 3 | Day 4 | Day 5 | Day 8 | Day 9 | Day 10 | Day 11 | Day 12 | ||
|---|---|---|---|---|---|---|---|---|---|---|---|
| Clinical signs and Imaging | Fever, headache, fatigue, dizziness Hemodynamic and respiratory stabile CT: ≈10% | Systemic Inflammatory Response Syndrome (SIRS) | Complementary paraclinical examinations | Nitrogen retention syndrome and SIRS decrease | CT ≈50-60% Severe form of SARS-CoV-2 pneumonia | ||||||
| Laboratory | Hematological | WBC: 6.720 cells/mm3 Neutrophils: 78% Lymphocytes: 13.8% RBC: 5,431,000 cells/mm3 Fibrinogen: 653.6 mg/dL | Neutrophils: 89.9% Lymphocytes: 6.2% | Neutrophils: 89% Lymphocytes: 6% | Hb: 15.4 g/dL pH: 7.54 pCO2: 55.4 mmHg SaO2: 91.4% | Hb: 15.4 g/dL pH: 7.54 pCO2: 55.4 mmHg SaO2: 91.4% | WBC: 12,730/mm3 Neutrophils: 87.3% Lymphocytes: 5.2% | ||||
| Metabolism | Glucose: 116 mg/dL | Glucose: 235 mg/dL | Glucose: 319 mg/dL Lactate: 15 mg/dL | Glucose: 319 mg/dL Lactate: 15 mg/dL | Glucose: 338 mg/dL | Ferritin: 1109 ng/mL Glucose: 327 mg/dL | |||||
| Liver function | ASAT: 46 IU/L GGT: 214 IU/L LDH: 458 IU/L Direct bilirubin: 0.33 mg/dL C-reactive protein: 19.29 mg/dL | C-reactive protein: 19.29 mg/dL INR: 5.26 | C-reactive protein: 9.77 mg/dL | C-reactive protein: 1 mg/dL | C-reactive protein: 1 mg/dL | ASAT: 25 IU/L, ALAT: 31 IU/L C-reactive protein: 0.65 mg/dL | C-reactive protein: 0.65 mg/dL | ||||
| Kidney function | BUN: 58 mg/dL Creatinine: 1.86 mg/dL Uric acid: 13 mg/dL | BUN: 70 mg/dL Creatinine: 1.59 mg/dL eGFR: 36.41 mL/min/1.73m2 | Creatinine: 1.12 mg/dL | BUN: 63 mg/dL Creatinine: 1.07 mg/dL eGFR: 58.78 mL/min/1.73m2 | BUN: 63 mg/dL Creatinine: 1.07 mg/dL eGFR: 58.78 mL/min/1.73m2 | BUN: 60 mg/dL Creatinine: 1.03 mg/dL eGFR: 81.55 mL/min/1.73 m2 | BUN: 60 mg/dL Creatinine: 1.03 mg/dL eGFR: 91.2 mL/min/1.73 m2 | ||||
| Microbiology | RT-PCR positive for SARS-CoV-2 Sputum sample collection | (+) Aspergillus section Flavi (−) Bacteriological Sputum sample collection | Aspergillus section Fumigati detected Galactomannan’s index: 0.65 Aspergillus antigen present | Galactomannan’s index: 0.65 Aspergillus antigen present | |||||||
| No. | Study | Year | Country | Patient (Age/Gender) | Species | Sample | GMI | BDG (pg/mL) | Anti-Fungal Treatment | Outcome | Diagnosis |
|---|---|---|---|---|---|---|---|---|---|---|---|
| 1 | Machado M et al. [3] | 2020 | Spain | 63/M | A. fumigatus + A. awamori + A. terreus | Bronchial aspirate | 0.56 | 5.4 | Isavuconazole (starting date not specified) | Death | Morphologic identification Galactomannan (GM) (1,3)-β-d-glucan (BDG) PCR |
| 2 | Nasir N et al. [16] | 2020 | Pakistan | 57/M | A. flavus + A. fumigatus | Sputa or tracheal aspirate | 0.272 | <7 | Amphotericin B (started on day 5) | Death | Morphologic identification Galactomannan (GM) (1,3)-β-d-glucan (BDG) |
| 3 | Abolghasemi S et al. [17] | 2021 | Iran | 66/F | A. Terreus + A. fumigatus (low colony count) | Mini-bronchoalveolarlavage | 4.15 | Not done | Voriconazole Caspofungin (started on day 21) | Death | Morphologic identification Galactomannan (GM) PCR |
| 4 | Marr K.A et al. [18] | 2021 | Spain | 70/M | A. fumigatus + A. niger | Tracheal aspirate/sputum | Not done | Not done | Voriconazole, posaconazole, or liposomal amphotericin B (starting date not specified) | Survived | Morphologic identification |
| 76/M | A. fumigatus + A. niger | CT scan | Not done | Negative | Survived | Morphologic identification | |||||
| 5 | Paramythiotou E et al. [19] | 2021 | Greece | 82/F | A. fumigatus + A. flavus | Bronchial secretions | 9.9 | 913.7 | Isavuconazole (started on day 11) | Death | Morphologic identification Galactomannan (GM) (1,3)-β-d-glucan (BDG) PCR |
| 66/M | A. fumigatus + A. terreus | 11.4 | 906.7 | Isavuconazole (started on day 6) | Survived | ||||||
| 6 | This study | 2021 | Romania | 53/F | Aspergillus section Fumigati + Aspergillus section Flavi | Sputum | 0.65 | Not done | Voriconazole (started on day 5) | Survived | Morphologic identification Galactomannan (GM) |
Publisher’s Note: MDPI stays neutral with regard to jurisdictional claims in published maps and institutional affiliations. |
© 2021 by the authors. Licensee MDPI, Basel, Switzerland. This article is an open access article distributed under the terms and conditions of the Creative Commons Attribution (CC BY) license (https://creativecommons.org/licenses/by/4.0/).
Share and Cite
Toc, D.A.; Costache, C.; Botan, A.; Mihaila, R.M.; Colosi, I.A.; Buksa, S.B.; Chiorescu, R.M. Mixed Etiology COVID-19 Associated Pulmonary Aspergillosis (CAPA)—A Case Report and Brief Review of the Literature. J. Fungi 2021, 7, 877. https://doi.org/10.3390/jof7100877
Toc DA, Costache C, Botan A, Mihaila RM, Colosi IA, Buksa SB, Chiorescu RM. Mixed Etiology COVID-19 Associated Pulmonary Aspergillosis (CAPA)—A Case Report and Brief Review of the Literature. Journal of Fungi. 2021; 7(10):877. https://doi.org/10.3390/jof7100877
Chicago/Turabian StyleToc, Dan Alexandru, Carmen Costache, Alexandru Botan, Razvan Marian Mihaila, Ioana Alina Colosi, Sandor Botond Buksa, and Roxana Mihaela Chiorescu. 2021. "Mixed Etiology COVID-19 Associated Pulmonary Aspergillosis (CAPA)—A Case Report and Brief Review of the Literature" Journal of Fungi 7, no. 10: 877. https://doi.org/10.3390/jof7100877
APA StyleToc, D. A., Costache, C., Botan, A., Mihaila, R. M., Colosi, I. A., Buksa, S. B., & Chiorescu, R. M. (2021). Mixed Etiology COVID-19 Associated Pulmonary Aspergillosis (CAPA)—A Case Report and Brief Review of the Literature. Journal of Fungi, 7(10), 877. https://doi.org/10.3390/jof7100877

